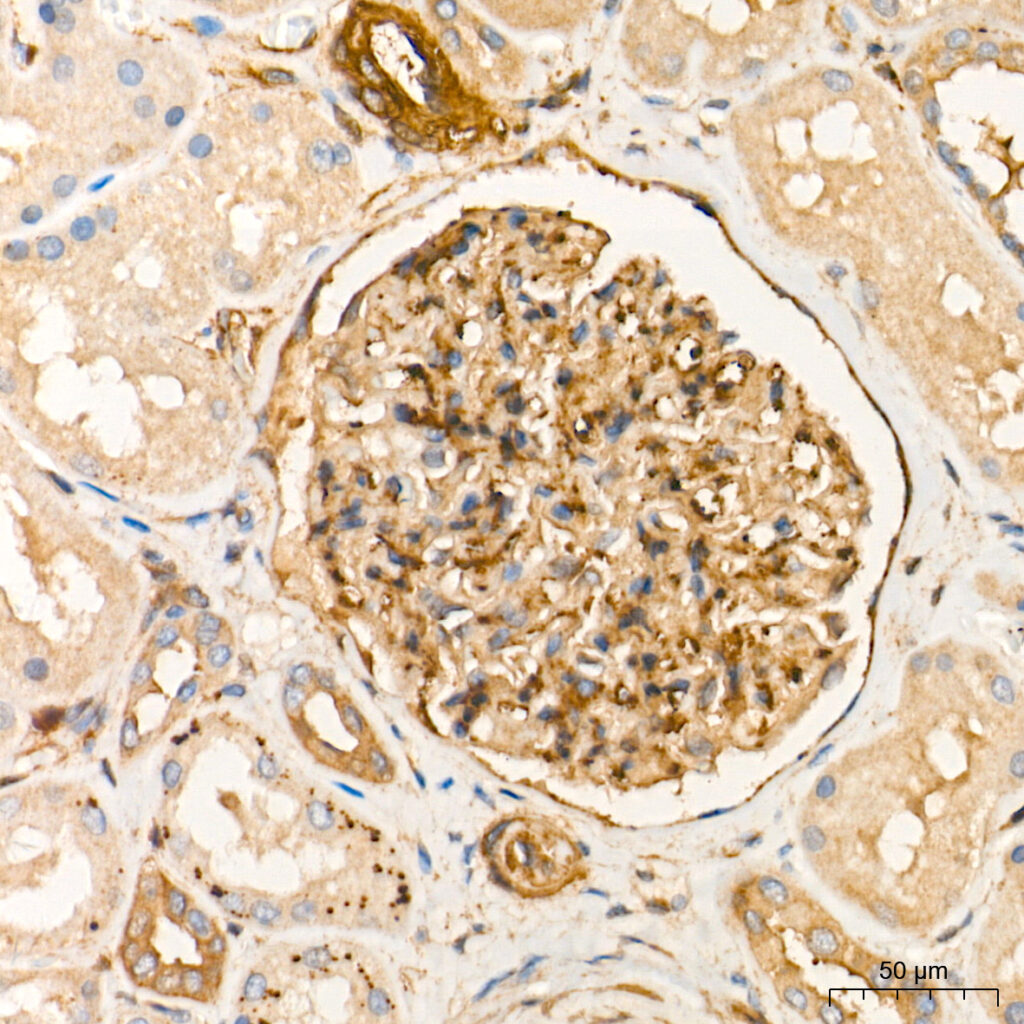
Immunohistochemistry analysis of paraffin-embedded Human kidney tissue using Vinculin Rabbit pAb at a dilution of 1:2000 (40x lens). High pressure antigen retrieval performed with 0.01M Tris-EDTA Buffer (pH 9.0) prior to IHC staining.
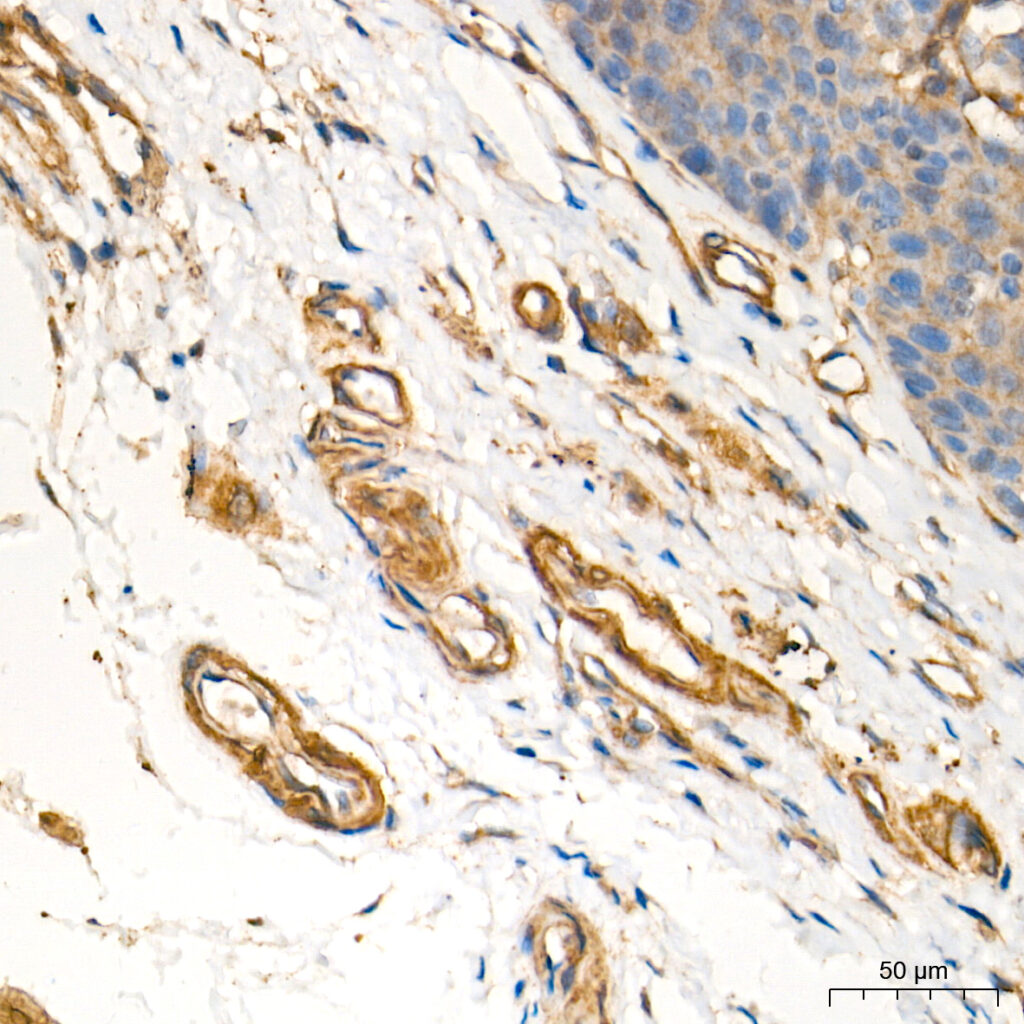
Immunohistochemistry analysis of paraffin-embedded Human esophagus tissue using Vinculin Rabbit pAb at a dilution of 1:2000 (40x lens). High pressure antigen retrieval performed with 0.01M Tris-EDTA Buffer (pH 9.0) prior to IHC staining.

Vinculin Rabbit Polyclonal Antibodies
| Cat Number: | AB14193 |
|---|---|
| Conjugate: | Unconjugated |
| Size: | 100 ug |
| Concentration: | 1mg/ml |
| Host: | Rabbit |
| Isotype: | IgG |
| Immunogen: | Recombinant protein.This information is considered to be commercially sensitive. |
| Reactivity: | Human,Mouse,Rat |
| Applications: | WB 1:500 - 1:1000 IF/ICC 1:50 - 1:200 ELISA Recommended starting concentration is 1 μg/mL. Please optimize the concentration based on your specific assay requirements. |
| Molecular: | 124kDa |
| Purification: | Affinity purification |
| Synonyms: | MV; MVCL; CMD1W; CMH15; HEL114; Vinculin |
| Background: | Vinculin is a cytoskeletal protein associated with cell-cell and cell-matrix junctions, where it is thought to function as one of several interacting proteins involved in anchoring F-actin to the membrane. Defects in VCL are the cause of cardiomyopathy dilated type 1W. Dilated cardiomyopathy is a disorder characterized by ventricular dilation and impaired systolic function, resulting in congestive heart failure and arrhythmia. Multiple alternatively spliced transcript variants have been found for this gene, but the biological validity of some variants has not been determined. |
| Form: | liquid |
| Buffer: | PBS containing 50% glycerol, preserved with proclin300 or sodium azide (as specified on the Certificate of Analysis), pH 7.3. |
| Storage: | Store at -20℃. Avoid freeze / thaw cycles. |

Western blot analysis of various lysates using Vinculin Rabbit pAb at 1:1000 dilution.
Secondary antibody: HRP-conjugated Goat anti-Rabbit IgG (H+L) at 1:10000 dilution.
Lysates/proteins: 25μg per lane.
Blocking buffer: 3% nonfat dry milk in TBST.
Detection: ECL West Plus.
Exposure time: 10s.
Immunohistochemistry analysis of paraffin-embedded Human kidney tissue using Vinculin Rabbit pAb at a dilution of 1:2000 (40x lens). High pressure antigen retrieval performed with 0.01M Tris-EDTA Buffer (pH 9.0) prior to IHC staining.
Immunohistochemistry analysis of paraffin-embedded Human esophagus tissue using Vinculin Rabbit pAb at a dilution of 1:2000 (40x lens). High pressure antigen retrieval performed with 0.01M Tris-EDTA Buffer (pH 9.0) prior to IHC staining.
